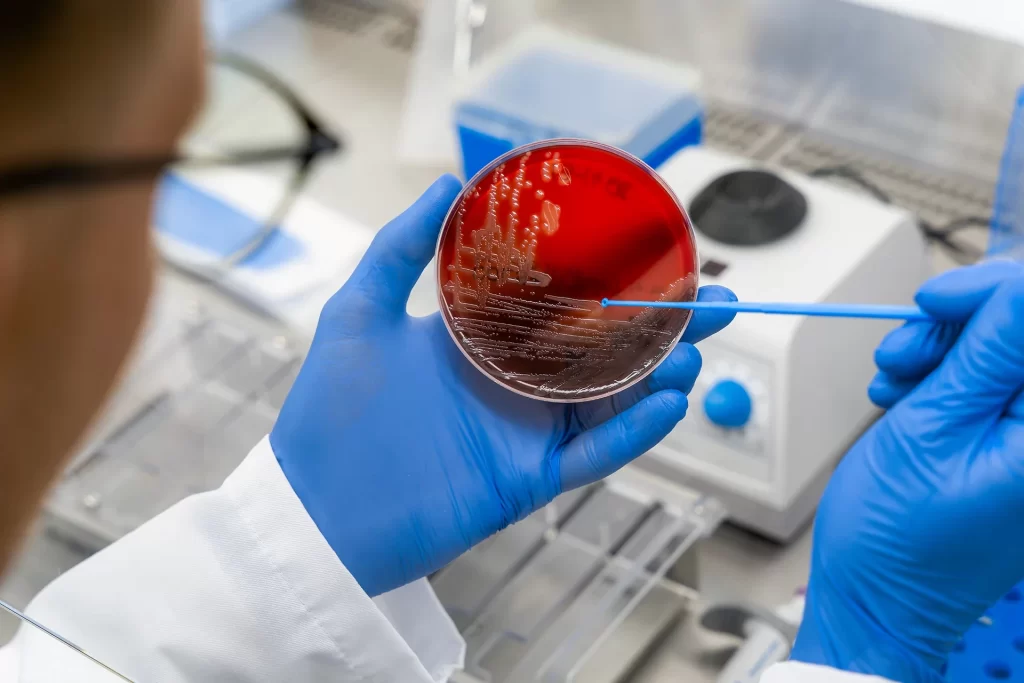
labolatorium

- BACTEROMIC
Edukacja
Czym jest antybiotykooporność i dlaczego stanowi zagrożenie?
Antybiotykooporność (oporność bakterii na działanie antybiotyku) występuje, gdy bakterie rozwijają oporność na antybiotyki, przez co leki te stają się mniej skuteczne lub nieskuteczne w leczeniu infekcji bakteryjnych. Jednym z głównych czynników przyczyniających się do rozwoju antybiotykooporności jest nadużywanie i niewłaściwe stosowanie antybiotyków, zarówno u ludzi, jak i u zwierząt. Przed zjawiskiem wytwarzania oporności przez drobnoustroje, przestrzegał już odkrywca pierwszego antybiotyku Alexander Fleming. Brak działań w kierunku zatrzymania antybiotykooporności może doprowadzić do braku możliwości leczenia infekcji bakteryjnych.

Niewłaściwe stosowanie środków przeciwdrobnoustrojowych

Bakterie rozwijają oporność

Środki przeciwdrobnoustrojowe stają się mniej skuteczne

Choroby łatwiej się rozprzestrzeniają
Jakie są powody powstawania antybiotykooporności?
Nadużywanie lub niewłaściwe stosowanie antybiotyków w medycynie, rolnictwie i weterynarii
Niewystarczająca profilaktyka zakażeń
Niestosowanie się do zaleceń lekarza przepisującego antybiotyk
Samoleczenie lub przerwanie terapii.
Antybiotyki nie leczą chorób wirusowych!
CZAS NA DZIAŁANIE JEST WŁAŚNIE TERAZ
MOŻEMY RAZEM PRZECIWDZIAŁAĆ ANTYBIOTYKOOPORNOŚCI
Najlepszym sposobem na walkę z antybiotykoopornością jest precyzyjna diagnostyka.
Nasze działania Edukacyjne
Firma Bacteromic koncentruje swoje działania nie tylko na rozwoju unikalnego systemu do identyfikacji bakteriooporności, lecz również na działaniach edukacyjnych, które skupiają się na zwiększaniu świadomości w zakresie problemu oporności na antybiotyki (AMR).
Wierzymy, że inwestowanie w rozwój młodych umysłów to inwestycja w przyszłość nas wszystkich.
Edukujemy, by chronić zdrowie. Bo edukacja naprawdę może ratować życie.

Wsparcie instytucji kultury i fundacji
Muzeum Farmacji / Oddział Muzeum Warszawy

W 2024 roku firma Bacteromic rozpoczęła współpracę z Muzeum Farmacji w Warszawie im. mgr. Antoniny Leśniewskiej. W 2025 roku spółka ponownie zdecydowała się wesprzeć tę instytucję. Wspólnie z edukatorami i edukatorkami muzealnymi podczas warsztatów dla dzieci i młodzieży przybliża problem oporności bakterii na działanie antybiotyków.
W 2024 roku dzięki partnerstwu spółki Bacteromic z warszawskim Muzeum Farmacji edukatorki i edukatorzy muzealni przeprowadzili 50 lekcji wzbogaconych o warsztaty na temat lekooporności. Przed nami 𝟲𝟱 kolejnych zajęć, które pomogą budować świadome nawyki, obalać mity i rozwijać odpowiedzialne podejście do antybiotyków.
Ponadto dzięki nawiązanej współpracy Muzeum przygotowało nową lekcją muzealną dla szkół ponadpodstawowych poświęconą zjawisku antybiotykooporności.
Od bakterii do leku - dlaczego antybiotyki nie zawsze działają?
Uczestnicy i uczestniczki zajęć prześledzą historię związków przeciwbakteryjnych od starożytności do dziś. Dowiedzą się, w jakich obszarach codziennego życia można zetknąć się z bakteriami i jakie środki ostrożności należy wtedy zachować. Omówią też rodzaje antybiotyków i zagłębią się w jeden z najważniejszych problemów dzisiejszej medycyny, czyli narastając antybiotykooporność.
Razem z Muzeum Farmacji tworzymy coś więcej niż projekt edukacyjny — tworzymy realną zmianę. I jesteśmy dumni, że możemy w niej uczestniczyć.
Fundacja Uniwersytet Dzieci
Spółka Bacteromic wsparła także działania edukacyjne Fundacji Uniwersytet Dzieci. W 2024 rok firma dofinansowała projekty „Planeta Zdrowia” oraz „Mali naukowcy. Ile chemii i fizyki jest wśród nas? Projekty te pozwalają dzieciom poznać i zrozumieć zagadnienia zdrowotne, a w przyszłości przyczynią się do podejmowania odpowiedzialnych decyzji.


Własne publikacje edukacyjne
Doktor Franek i Bakteriusz, czyli jak nie dać się chorobie to autorska książka spod skrzydeł Bacteromic o problemie antybiotykooporności i rozsądnym leczeniu, skierowana do najmłodszych – przedszkolaków i uczniów pierwszych klas podstawówki.
Głównym bohaterem naszej książki jest Bakteriusz, który wraz młodymi kompanami i doktorem Frankiem opowiada czytelnikom o rozsądnym leczeniu.
To wspaniali przewodnicy, którzy przeprowadzają dzieci przez problem oporności na antybiotyki. Nasza ciepła i pouczająca historia pokazuje, jak ważne jest prawidłowe leczenie i dbanie o zdrowie. Razem z małymi bohaterami i Bakteriuszem dzieci dowiedzą się, kiedy naprawdę warto sięgać po lekarstwa i jak zostać małym strażnikiem odporności.
Zobaczcie sami!